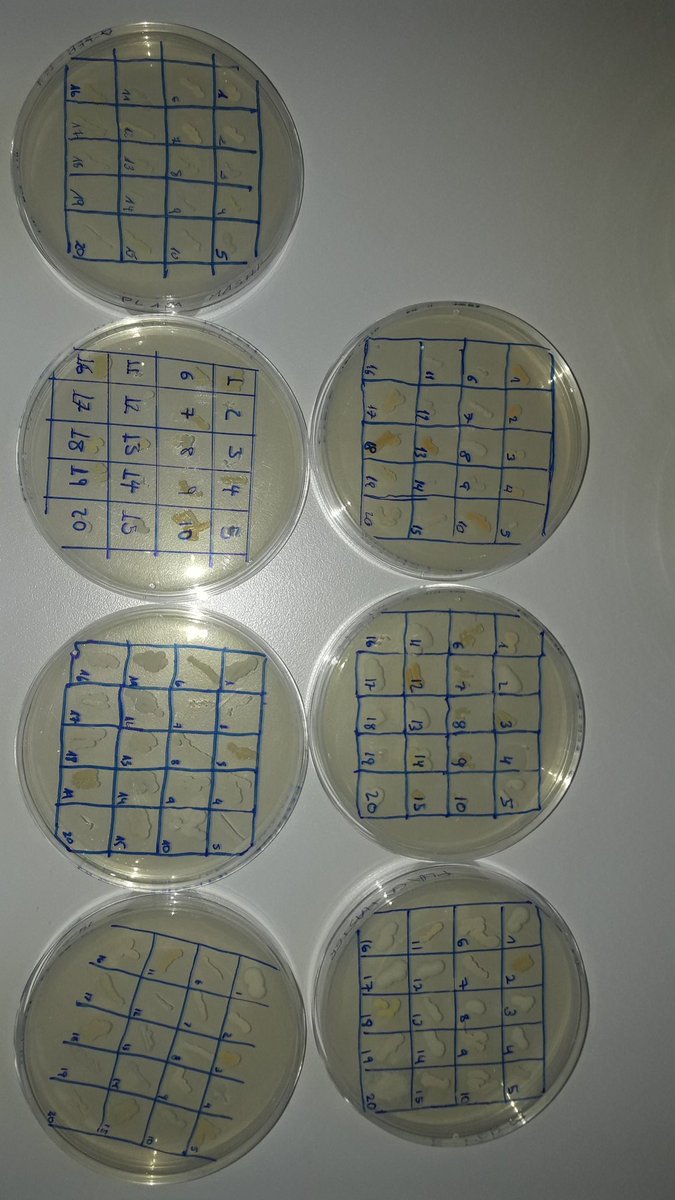
Hui farem sessions del SWI quasi simultànies a <a href="/ii_ies/">IES Jaume II el Just</a>, @iesfmontseny, <a href="/iesxdu/">IES XIMÉN D'URREA</a> i <a href="/iesbenigaslo/">IES BENIGASLÓ</a> Quien da mas?

IES Jaume II el Just
@ii_ies
ID: 1070634804385931264
06-12-2018 11:03:23
83 Tweet
69 Takipçi
317 Takip Edilen

Hui farem sessions del SWI quasi simultànies a IES Jaume II el Just, @iesfmontseny, IES XIMÉN D'URREA i IES BENIGASLÓ Quien da mas?

Totes les dones poden arribar tant lluny com imaginen. És el moment de demostrar que dónes i hòmens som iguals. El moment de sumar-se a les dones que ja han fet dels seus somnis una realitat #VullSerCom Patricia Campos @conchagzaera @albarecheot2018 Carolina Ferre #MariaBlascoMarhuenda



🗣️ Jo de major vull ser artista, entusiasta, dona i pensadora #8març 📚 Les paraules i les imatges de les xiquetes evolucionaran, es faran grans i contaran històries que trobarem demà als llibres. ♀️ Les xiquetes de hui en dia seran referents! Àmbit d’Educació Infantil Formació, Innovació i Recursos per al Professorat






















